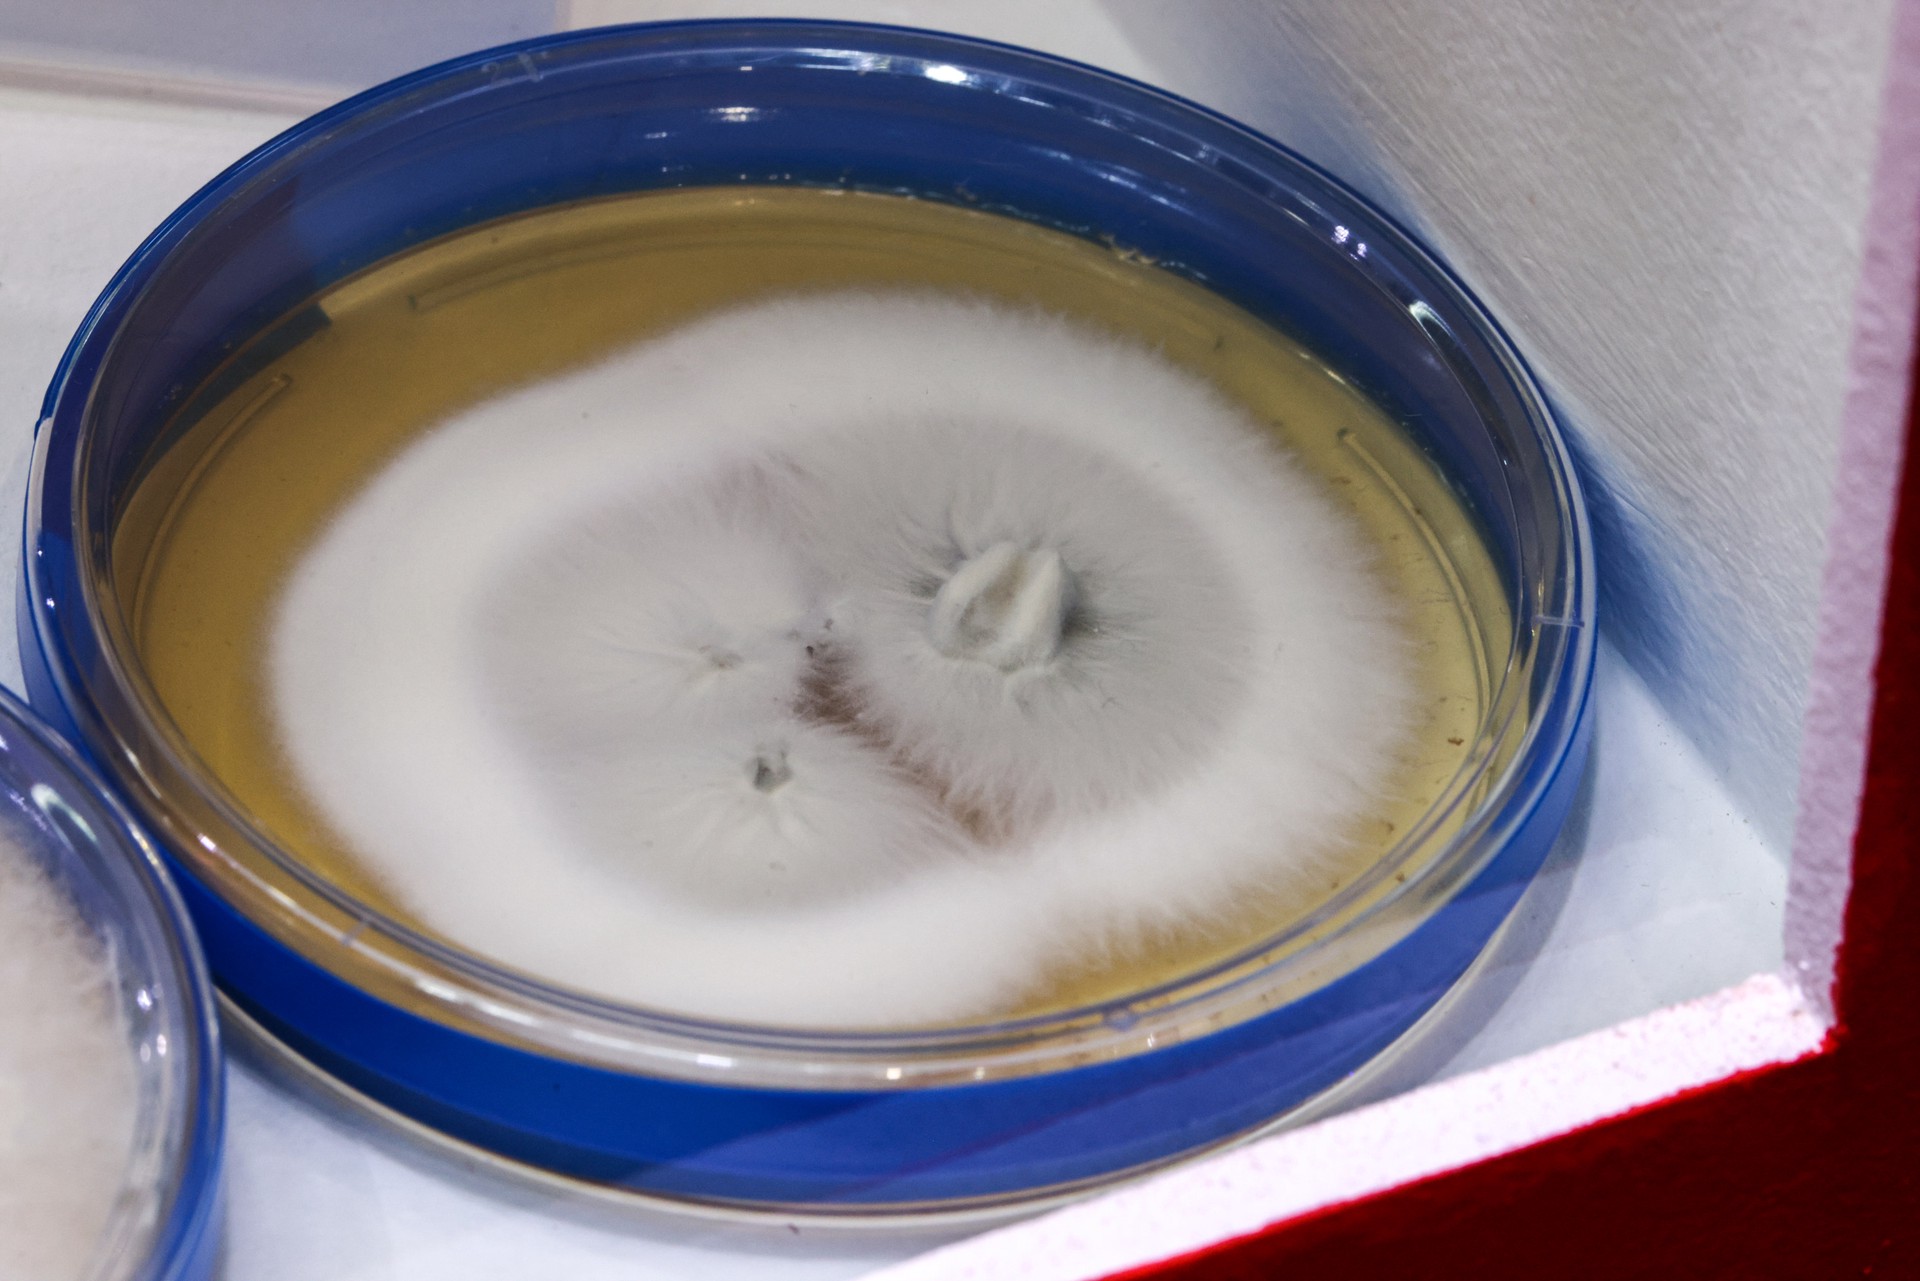
Опасный супергрибок распространяется по Европе

Опасный супергрибок распространяется по Европе
По Европе стремительно распространяется устойчивый к лечению опасный грибок Trichophyton indotineae, который называют «супергрибком», сообщает The Sun.
По словам эксперта по инфекционным заболеваниям Манчестерского университета Дэвида Деннинга, грибок вызывает красные зудящие высыпания – в основном в паху, на бедрах и ягодицах.
За последние три года количество случаев заражения Trichophyton indotineae в Великобритании увеличилось почти на 500%. Супергрибок распространяется через прямой контакт с инфицированным человеком, загрязненные поверхности, бытовые предметы или половым путем.
Заболевание не несет угрозы для жизни, но с трудом поддается лечению. Пациенты должны проходить курсы терапии по несколько недель или даже месяцев. По мнению эксперта, этот супергрибок станет большой проблемой для всего мира.
Ранее сообщалось, что из-за отказа от вакцинации вспышки кори неизбежно продолжаются и именно низкий охват прививками делает ситуацию нестабильной. Опыт предыдущих лет показал, что даже единичные заносы инфекции быстро приводят к локальным вспышкам, если население недостаточно защищено.

